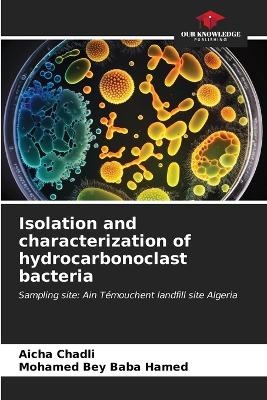
Isolation and characterization of hydrocarbonoclast bacteria - Aicha Chadli, Mohamed Bey Baba Hamed

Isolation and characterization of hydrocarbonoclast bacteria
Seiten
2023
Our Knowledge Publishing (Verlag)
978-620-6-67022-3 (ISBN)
Our Knowledge Publishing (Verlag)
978-620-6-67022-3 (ISBN)
- Keine Verlagsinformationen verfügbar
- Artikel merken
Microbiological analysis of hydrocarbon biodegrading bacteria isolated from leachate collected from the Ain Témouchent C.E.T. revealed that they belonged to the Pseudomonadaceae and Staphylococcaceae families. Biochemical tests revealed the presence of : Pseudomonas aeruginosa (Ps), Pseudomonas fluorescens (38 ) and Pseudomonas sp (98), Staphylococcus aureus (St), Staphylococcus xylosus (5), Staphylococcus hominis (78 ) and Staphylococcus warnerii (28). The latter were molecularly characterized by genomic DNA extraction and amplification of the 16S rDNA gene using universal primers. These bacteria were tested for the presence of the degradation gene catechol 2,3-dioxygenase (C230), by PCR amplification using primers specific to the latter. Of the seven strains studied, only Pseudomonas strains possessed this gene. The protein profile of the seven bacterial strains was then studied, enabling better characterization of hydrocarbonoclastic bacterial species...
Dr Aicha Chadli, Doctor in 3rd cycle LMD and lecturer class B at the École supérieure d'agronomie de Mostaganem (Algeria). Field: Natural and Life Sciences, major: Biology, specialty: Applied Microbiology, option: Microbiological control and food hygiene. I teach Microbiology.
| Erscheinungsdatum | 17.11.2023 |
|---|---|
| Sprache | englisch |
| Maße | 152 x 229 mm |
| Gewicht | 137 g |
| Themenwelt | Naturwissenschaften ► Biologie ► Allgemeines / Lexika |
| Naturwissenschaften ► Biologie ► Mikrobiologie / Immunologie | |
| Schlagworte | bactéries hydrocarbonoclastes • CET • Hydrocarbonoclastic bacteria • Hydrocarbons • hydrocarbures • leachate • lixiviat • Pseudomonas |
| ISBN-10 | 620-6-67022-8 / 6206670228 |
| ISBN-13 | 978-620-6-67022-3 / 9786206670223 |
| Zustand | Neuware |
| Informationen gemäß Produktsicherheitsverordnung (GPSR) | |
| Haben Sie eine Frage zum Produkt? |
Mehr entdecken
aus dem Bereich
aus dem Bereich
Buch | Softcover (2024)
Wiley-VCH (Verlag)
CHF 55,85
Band 2: Elektrizität, Optik und Wellen
Buch | Softcover (2022)
Wiley-VCH (Verlag)
CHF 55,85
Vom Ursprung der Sexualitat zum modernen Menschen
Buch | Softcover (2025)
UTB (Verlag)
CHF 54,60


